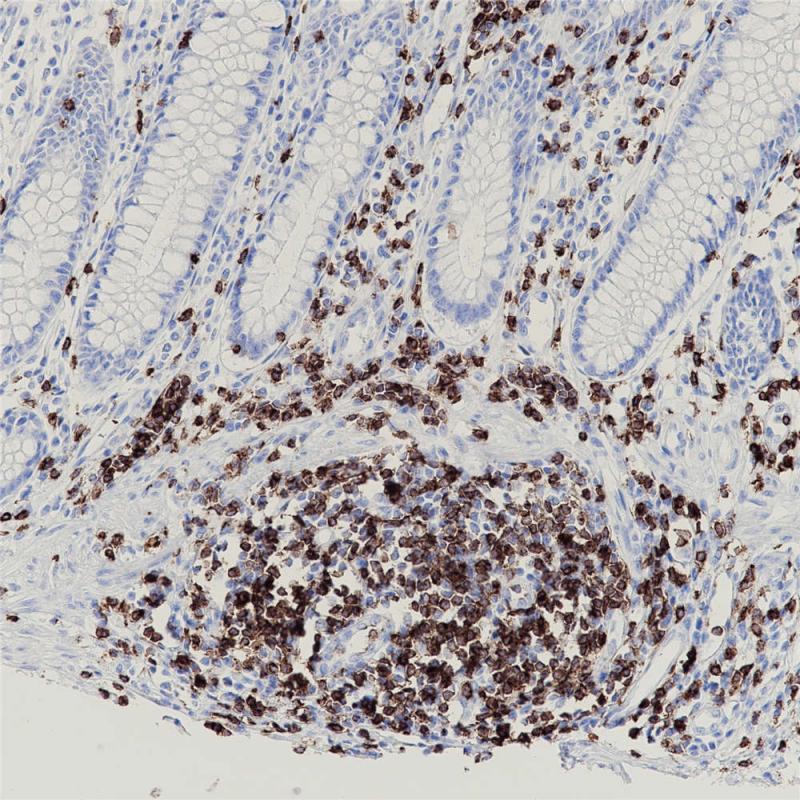
阑尾 CD2 (BP6107) 染色

产品中心

扁桃体 CD2 (BP6107) 染色
阑尾 CD2 (BP6107) 染色
CD2 重组兔单克隆抗体
CD2主要存在于成熟的T细胞和NK细胞膜表面, 而B细胞通常不表达,可标记正常T细胞及其相关肿瘤,如前T细胞淋巴瘤、边缘T细胞淋巴瘤和间变大细胞淋巴瘤的诊断与研究。
Specifications
- 目录号
- BX50102
- 克隆号
- BP6107
- 阳性对照
- T细胞淋巴瘤
- 亚细胞定位
- 细胞膜
- 组织类型
- FFPE
- 修复方式
- HIER
- 稀释比
- 1:100-1:200
- 规格
- 100μl/vial, 1ml/vial
- 用途
- RUO
Reference
1.Companioni Nápoles O, et al. J Gastroenterol 52:39-49 (2017).
2. DE Sanctis V, Belgioia L, et al. ANTICANCER RESEARCH 39: 1935-1942 (2019).


